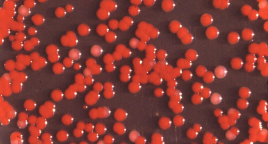
Serratia marcescens

페이지를 불러오는 중입니다. 잠시만 기다려주세요...
0%
습한 실내 환경에서는 미생물이 쉽게 정착합니다. 특히 욕실과 화장실은 온도 변화, 수분 잔류, 비누 찌꺼기 등 유기물 요소가 결합되면서 특정 미생물 군집이 형성되기 좋은 구조입니다. 이 과정에서 핑크색 물때가 반복적으로 보이는 현상이 발생합니다. 욕실과 화장실 핑크색 물때 제거 방법을 이해하려면, 먼저 이 물질의 정체와 성장 조건을 정확히 파악해야 합니다.

핑크색 물때의 정체
대부분의 경우 이 핑크색 물질은 곰팡이가 아니라 세라티아 마르세센스(Serratia marcescens)라는 세균이 형성한 군집입니다.
특징은 다음과 같습니다.
- 습기·비누 찌꺼기·피부 유분 등 유기물 환경에서 증식
- 표면에 슬라임(점액질)과 색소 침착 생성
- 배수구 주변, 샤워기 틈, 실리콘 이음새에 흔함
곰팡이류와 달리 유기물 분해 능력과 점액 보호막이 강해 관리가 소홀하면 반복됩니다.
왜 자꾸 생길까
- 사용 후 물기 잔류
- 통풍 부족
- 세정 성분과 유분이 표면에 남음
- 온도 상승(미생물 활동 촉진)
즉, 습기 + 유기물 + 따뜻함이 결합되는 순간 환경이 만들어집니다.

욕실과 화장실 핑크색 물때 제거 방법
효과적인 제거는 단순 세척이 아니라 막 구조 파괴 + 소독 + 물기 제거 순서가 필요합니다.
권장 절차
- 거품형 세정제 또는 베이킹소다+식초 반응 거품을 표면에 도포
- 5~10분 후 부드러운 브러시로 문질러 점액층 제거
- 미지근한 물로 헹굼
- 락스 희석액 또는 과산화수소로 소독 처리
- 완전 건조
주의
- 락스와 산성 세제 혼합 금지
- 실리콘 이음새는 너무 강하게 문지르지 않기
정리하면, 세균의 바이오필름(보호막)을 먼저 깨고 이후 소독을 적용해야 합니다.

예방 방법
반복 생성을 줄이려면 환경 조건을 바꿔야 합니다.
- 샤워 후 물기 제거(스크레이퍼 또는 마른 수건)
- 환풍기 최소 20~30분 가동
- 주 1~2회 약산성 세정으로 표면 관리
- 배수구 주변 거품 잔여물 수시 제거
특히 비누 찌꺼기 제거 + 건조가 가장 효과적인 전략입니다.

마치면서
욕실과 화장실 핑크색 물때 제거 방법은 단순 청소가 아니라 미생물 환경을 관리하는 과정입니다. 반복되는 붉은 곰팡이처럼 보이지만 실제로는 세라티아 마르세센스 세균의 점액막 때문이며, 보호층 파괴와 건조 습관이 가장 중요합니다. 꾸준한 관리가 가장 확실한 예방 수단입니다.

화장실 핑크색 곰팡이는 몸에 해로운가요?
면역력이 약한 경우 감염 위험이 있을 수 있어 정기적인 제거가 필요합니다.
천연 세제로만 해결할 수 있나요?
가능하나 소독력이 약할 수 있어 주기적인 강한 살균이 도움이 됩니다.
함께하면 좋은 글
반응형




